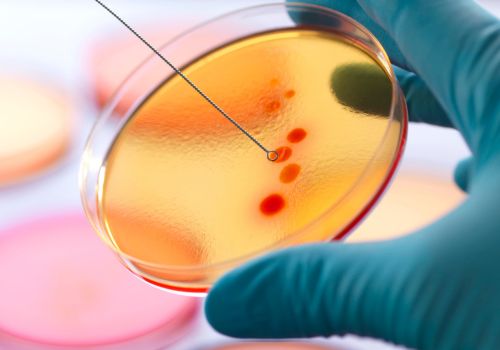

La Fundación Francisco Soria Melguizo acaba de lanzar la convocatoria de sus Ayudas a la Investigación Biomédica 2023, dotadas con 600.000 euros, y que en esta nueva edición irán destinadas a financiar proyectos de investigación en dos ámbitos temáticos: la resistencia a los antimicrobianos y el abordaje de la fragilidad desde la perspectiva de la gerotecnología. El plazo de presentación de solicitudes está abierto hasta el 19 de octubre.
Con el lanzamiento de estas Ayudas, la Fundación Francisco Soria Melguizo pretende promover e impulsar la investigación y el avance del conocimiento biomédico mediante investigaciones de excelencia, innovadoras y con orientación traslacional que puedan contribuir en la lucha contra problemas de salud de la máxima relevancia y que tengan alto impacto social. La convocatoria de 2023 consolida la labor de mecenazgo científico de la Fundación, que ya destinó casi tres millones de euros a distintas iniciativas de apoyo a la investigación y a la divulgación del conocimiento en salud en los ejercicios de 2020, 2021 y 2022. Además, da continuidad a las áreas de investigación a las que la entidad viene dirigiendo sus ayudas en anteriores ejercicios.
Nuevas tecnologías en el estudio de la resistencia a antimicrobianos
La primera sección de esta nueva convocatoria está dirigida en exclusiva a grupos integrados en el Centro de Investigación Biomédica en Red (CIBER) y financiará con 300.000 euros el estudio sobre la resistencia a los antimicrobianos entre los grupos de población vulnerable, apoyando un proyecto que plantee propuestas innovadoras.
En este campo, que representa uno de los mayores desafíos presentes y futuros para la ciencia biomédica, la convocatoria pretende alentar propuestas que incluyan en su abordaje la aplicación de nuevas tecnologías o herramientas de inteligencia artificial, en la generación o análisis de datos.
Gerotecnología para el abordaje de la fragilidad
La segunda sección de la convocatoria de Ayudas 2023, abierta a grupos de universidades, centros de investigación, empresas y otras organizaciones tanto del ámbito público como del privado, destinará asimismo 300.000 euros a financiar una investigación en el ámbito gerontológico.
En esta ocasión, la Fundación apuesta por una perspectiva que enlaza con la gerociencia o gerotecnología, y apoyará una investigación que aborde el problema de la fragilidad y/o la capacidad intrínseca de los mayores desde la perspectiva tecnológica (uso de sensores, desarrollo de plataformas globales de aproximación clínica al paciente en su domicilio, aplicación de la inteligencia artificial…), tanto con propósito diagnóstico, como de intervención, preventiva o terapéutica, y seguimiento, bien de manera aislada o de forma global.
Procedimiento de presentación de solicitudes y resolución
A la primera ayuda podrán concurrir grupos de investigación pertenecientes al Centro de Investigación Biomédica en Red (CIBER), implicando a investigadores de al menos dos áreas temáticas del CIBER relacionadas con el objeto de la investigación. A la segunda podrán presentarse grupos de investigación de universidades, hospitales, centros de investigación, públicos o privados, así como de empresas y otras organizaciones con personalidad jurídica propia cuyo investigador principal figure adscrito a un centro español.
Todas las candidaturas deberán presentarse mediante el cumplimento del impreso de solicitud que deberá remitirse a la dirección de mail ayudas2023@fundacionsoriamelguizo.org, indicando en el asunto Convocatoria ayudas 2023 Fundación Francisco Soria Melguizo, el número de sección a la que se presenta (1 ó 2) y el nombre del investigador principal.
El plazo de presentación de las solicitudes concluirá el 19 de octubre de 2023, a las 20:00 horas.
Las solicitudes recibidas se someterán a un proceso de selección por parte de una comisión evaluadora, designada por la Fundación Soria Melguizo, compuesta por expertos de reconocido prestigio. La resolución se hará pública no más tarde del 15 de diciembre de 2023 en la página web de la Fundación (www.fundacionsoriamelguizo.org).
Los proyectos de investigación presentados que resulten ganadores deberán llevarse a cabo durante un periodo máximo de 24 meses
VER BASES DE LA CONVOCATORIA